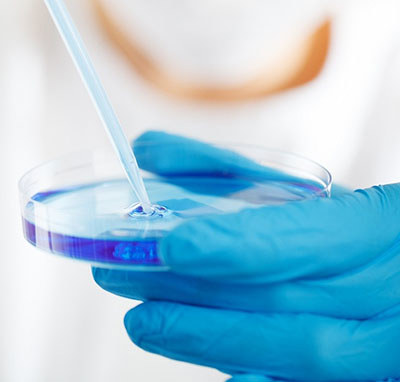
Academic and Medical Research Funding

HonorHealth Academic Medicine
"At HonorHealth, we rally around the philosophy that it takes a learning health system to address the health needs of our communities."
— Todd LaPorte, Chief Executive Officer, HonorHealth
 Academic medicine is the seamless integration of clinical patient care, research and medical education, where the pursuit of knowledge meets the art of healing. It represents our commitment to advancing medical science, training the next generation of healthcare leaders and delivering innovative, evidence-based care to you, your family and our world.
Academic medicine is the seamless integration of clinical patient care, research and medical education, where the pursuit of knowledge meets the art of healing. It represents our commitment to advancing medical science, training the next generation of healthcare leaders and delivering innovative, evidence-based care to you, your family and our world.
In a community healthcare system like HonorHealth, academic medicine defines a deeper purpose: blending the personalized, compassionate care of a local hospital with the groundbreaking discoveries and expertise of leading medical research.
It creates a dynamic environment where patients benefit from the latest advancements in medicine, and the community thrives from a system dedicated not just to treating illness but to transforming health for generations to come.
The student experience will draw from multiple disciplines like the humanities, biological sciences, AI, medical engineering, community care and more. This training will create a healthcare leader with a strong sense of innovation, problem-solving, empathy, systems thinking and comfort with new devices and protocols in treatment.
This unprecedented approach to health created by HonorHealth and ASU will transform how healthcare is designed, delivered and measured, while producing tomorrow’s healthcare leaders who are focused every day on the well-being of our community and beyond.
If you would like to receive updates or discuss opportunities for your involvement, please contact us: 480-587-5000 or Foundation@HonorHealth.com
 In 2024, HonorHealth was named the primary clinical affiliate for the Arizona State University John Shufeldt School of Medicine and Medical Engineering.
In 2024, HonorHealth was named the primary clinical affiliate for the Arizona State University John Shufeldt School of Medicine and Medical Engineering.
ASU continues to be nationally ranked #1 in Innovation, making the institution a tremendous partner for HonorHealth, with its innovative healthcare advancements.
HonorHealth and ASU will produce physicians who blend medicine, engineering, technology and humanities to become a different kind of healthcare leader. Graduates will leverage new tools such as AI and data science to connect with more patients and seek innovative practices.
Together, we will grow the talent, clinical programs and research needed to create a world class academic medical institution. As we train future leaders in medicine and medical engineering, we will improve clinical outcomes, making care more personalized and more effective.
"Our alignment with ASU Health and the ASU John Shufeldt School of Medicine and Medical Engineering will further enhance HonorHealth’s position as the most innovative, highest quality integrated healthcare delivery network in the state of Arizona."
— John Neil, MD, MMM, HonorHealth EVP, Chief Physician Executive and Network Strategy Officer
If you would like to receive updates or discuss opportunities for your involvement, please contact us: 480-587-5000 or Foundation@HonorHealth.com
Philanthropists not only provide resources and opportunities, but they drive social change. Your transformational investment in HonorHealth Academic Medicine means you’re supporting more than great care — your generosity will make groundbreaking, innovative advancements possible while training a new generation of healthcare professionals!
Below are ways you can support HonorHealth Academic Medicine.
Recruit and Retain Top Talent
Patrons of Promise Endowed Chair Program
 Endowed chairs are a hallmark of academic medical institutions. Top faculty play a pivotal role in driving HonorHealth’s national reputation and shaping the professional paths of students. Endowed faculty professorships ensure that HonorHealth has the resources to recruit and retain the best and brightest faculty.
Endowed chairs are a hallmark of academic medical institutions. Top faculty play a pivotal role in driving HonorHealth’s national reputation and shaping the professional paths of students. Endowed faculty professorships ensure that HonorHealth has the resources to recruit and retain the best and brightest faculty.
A Chair is the highest honor and the pinnacle of one’s career as a faculty leader and researcher. A Professorship is typically provided to a promising earlier career clinical faculty and researcher.
Supporting endowed Chairs and Professorships will:
- Advance and develop the specialties of HonorHealth’s world class clinicians
- Champion the latest in healthcare innovation
- Drive the latest in cutting edge research and new treatment options
- Provide support to hire talented faculty and staff for medical education, research and clinical initiatives
All play an important role in helping HonorHealth lead research and move patient-centered healthcare forward on a national scale. Through your generosity, we are poised to retain distinguished service line leaders who excel in education, research and innovation by providing financial support for their research and teaching activities.


Clinical Experience Endowments
 Investing in clinical experience endowments will support a network of preceptorships. These hands-on mentoring experiences pair students with practicing physicians, allowing them to immerse themselves in real-world clinical environments.
Investing in clinical experience endowments will support a network of preceptorships. These hands-on mentoring experiences pair students with practicing physicians, allowing them to immerse themselves in real-world clinical environments.
Clinical experience funds will ensure that future doctors are not only well-trained but also deeply connected to the communities they serve, ultimately leading to improved patient care.
Academic and Medical Research Funding
HonorHealth Research Institute’s clinical leaders and physician-scientists conduct cutting-edge clinical trials to make discoveries at the forefront of healthcare, to improve treatment options for patients in Arizona and throughout the country.
HonorHealth Research Institute’s clinical leaders and physician-scientists conduct cutting-edge clinical trials to make discoveries at the forefront of healthcare, to improve treatment options for patients in Arizona and throughout the country.
Your investment in academic and medical research supports groundbreaking initiatives that lead to medical advancements and improved patient outcomes, while fostering a culture of scientific inquiry and discovery.
A Place of Knowledge
 More than just new buildings, HonorHealth’s expansion promises a truly unique patient and clinician experience, grounded in our pursuit of cutting-edge patient care. With your support, HonorHealth will continue to advance the innovative services we provide to patients and their families.
More than just new buildings, HonorHealth’s expansion promises a truly unique patient and clinician experience, grounded in our pursuit of cutting-edge patient care. With your support, HonorHealth will continue to advance the innovative services we provide to patients and their families.
An investment in clinical training facilities and programs provides hands-on, real-world experiences, ensuring our graduates are well-prepared for the complexities of patient care today and well into the future.
Technology and Innovation
 Technology and innovation are the backbone of all healthcare education. Simulation allows teaching through guided experiences in safe contexts, facilitating adequate learning and standardized assessment of the skills necessary to practice in a rapidly changing world.
Technology and innovation are the backbone of all healthcare education. Simulation allows teaching through guided experiences in safe contexts, facilitating adequate learning and standardized assessment of the skills necessary to practice in a rapidly changing world.
Investments in simulation opportunities include life-like learning Manikins (mannequins), revolutionary robotics, procedure simulators, faculty development and more.
Additional technology and innovation investment opportunities include:
- State-of-the-art learning labs
- Large auditoriums
- Technologically advanced learning and meeting spaces
- Simulation centers
- Classrooms
Naming Gifts and Legacy Giving

At HonorHealth, a name is a valued and treasured gift. Its significance is evident by the number of successful endowment campaigns throughout the Foundation’s history and by the hundreds of named areas throughout our medical facilities commemorating donor generosity.
Your named endowment serves as a permanent — and personal — legacy. Your investment ensures the future of healthcare through the dedication of the endowment holder.
Named giving opportunities include:
- Distinguished Endowed Chair
- Endowed Chair
- Endowed Professorship
- Funds established for research, scholarships, innovative programs, technology and equipment
- A focused philanthropic plan that supports biomedical discovery, clinical innovation and world-class medical education
If you would like to receive updates or discuss opportunities for your involvement, please contact us: 480-587-5000 or Foundation@HonorHealth.com